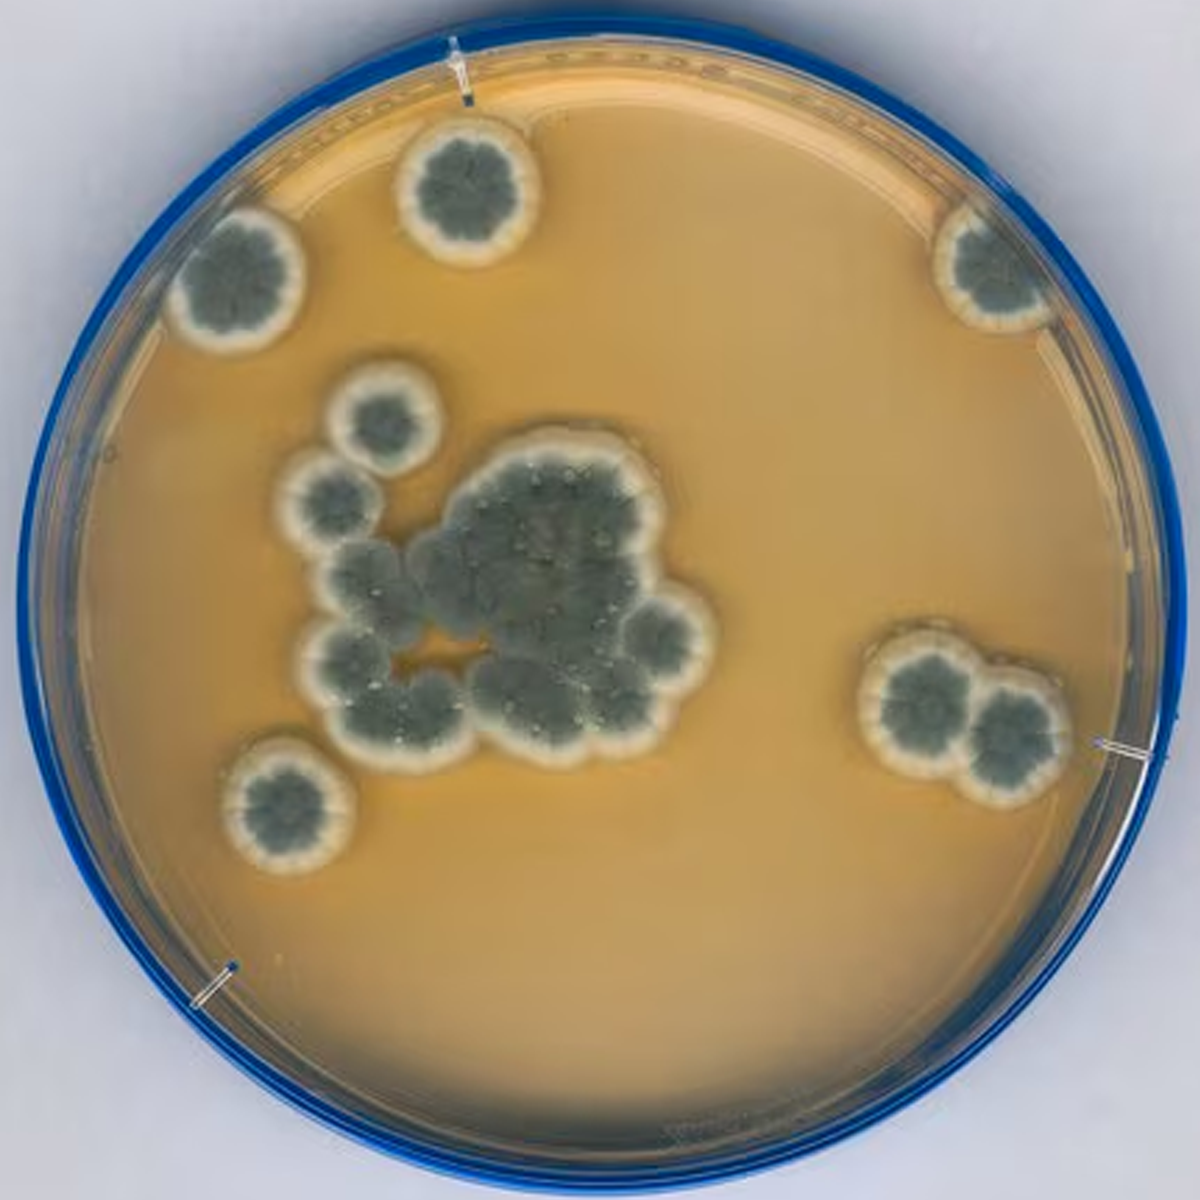

1
/
of
1
SKU:1465010020
Merck
Sabouraud Dextrose Agar
Sabouraud Dextrose Agar
Out of stock
Product description
Product description
Sodium thiosulphate, Tween®, Lecithin, Histidine, lid, ICR plus - lockable contact plate, plate diam. 55 mm, sterile; irradiated, triple packed of 20 or 200 plates, suitable for surface monitoring
Additional information
Additional information